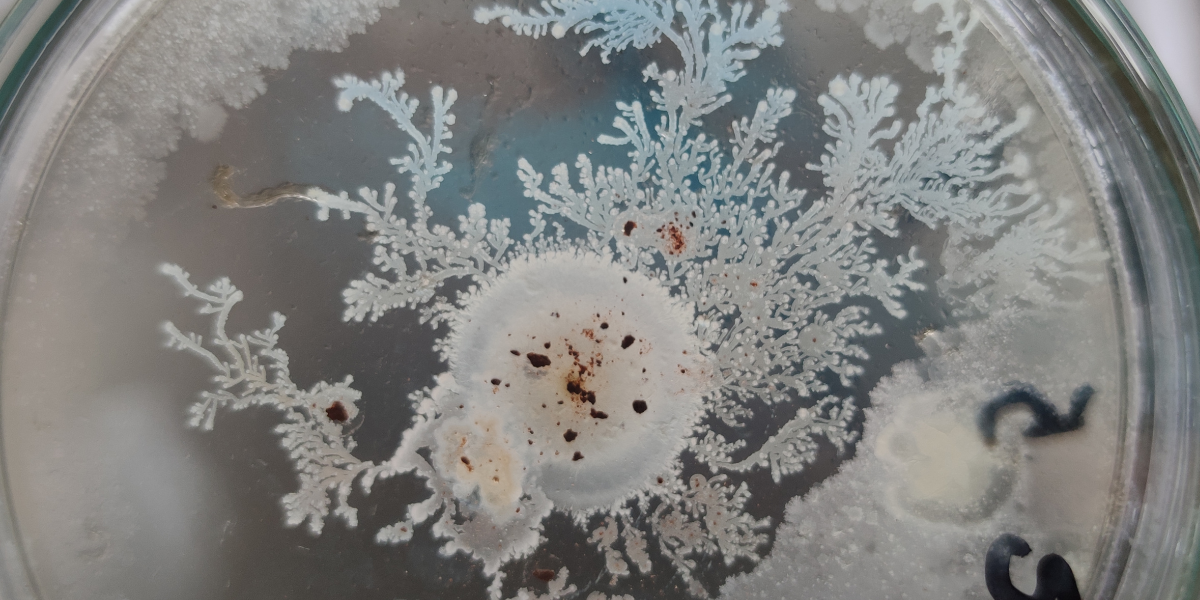

Negli ultimi anni, sempre più appassionati di giardinaggio stanno scoprendo l’efficacia dei prodotti a base di microrganismi utili, un valido aiuto naturale per migliorare la salute delle piante, ridurre l’uso di fitofarmaci e affrontare i problemi più comuni in giardino, dal terreno impoverito agli attacchi di insetti o malattie fungine.
Tra i prodotti più richiesti: Beauvum, Bacillium, Tricum, Bioseed e Turikum, tutti ricchi di funghi micorrizici, batteri della rizosfera o ceppi specifici di entomoparassiti e antagonisti naturali dei patogeni.
In questo articolo rispondiamo alle domande più frequenti su come e quanto utilizzarli, fornendo anche esempi pratici legati ad alberi ornamentali e coltivazioni da orto comuni.
Perché usare i microrganismi?
I microrganismi nei prodotti Unmaco sono utili per diversi scopi:
- Migliorano lo sviluppo dell’apparato radicale
- Aumentano la disponibilità e l’assorbimento di nutrienti
- Rendono le piante più resistenti agli stress ambientali (caldo, siccità, terreno povero)
- Contrastano larve di insetti nocivi e patogeni fungini attraverso azione parassitaria o di competizione
- Riducono la necessità di usare prodotti chimici
Ma attenzione: tutti i microrganismi sono naturalmente dormienti. Per risvegliarli rapidamente e renderli più attivi ed efficaci, si consiglia di mescolarli a un concime organico liquido ricco di azoto, come Nutribio N. Questo fornisce “cibo” ai microrganismi, aumentando la loro sopravvivenza nel suolo e il successo del trattamento.
Quando usarli?
Il momento ideale per l’applicazione è:
- Primavera, estate e autunno, quando il suolo è caldo e attivo
- Dopo trapianti o rinvasi, per favorire la radicazione
- Prima o durante attacchi di insetti o malattie fungine
- Dopo stress da caldo, siccità o potature
Si può ripetere l’applicazione ogni 2-4 settimane. In caso di trattamenti frequenti (es. ogni 15 giorni), è possibile ridurre leggermente il dosaggio. L’importante è operare sempre nelle ore più fresche della giornata e non in pieno sole.
Dosaggi consigliati e casi pratici
Tutti i dosaggi sono riferiti alle concentrazioni standard dei prodotti Unmaco. Usare sempre abbondante volume d’acqua per facilitare la distribuzione e l’arrivo dei microrganismi vicino alle radici.
🌿 Beauvum
Micorrize + funghi entomoparassiti (Beauveria e Metarhizium)
Funzione principale: controllo biologico di larve di insetti come Popillia japonica, oziorrinco, afidi, acari, aleurodidi, cocciniglie, maggiolino, tripidi, ecc. tramite degradazione della cuticola.
Dosaggi:
- Radicale: 10-20 ml per 100 m²
- Fogliare: 20-30 ml in 10 L d’acqua
- Tappeto erboso: radicale – 20 ml in 100 L d’acqua per 100 m²
Esempio d’uso: su piante ornamentali attaccate da larve nel terreno (come rose, ligustri o agrumi), distribuire alla base e sulle foglie per contrastare l’insetto in tutte le fasi vitali.
🍂 Tricum
Micorrize + 4 ceppi di Trichoderma
Funzione principale: protezione da funghi patogeni (Pythium, Fusarium, Rhizoctonia, Phytophthora, ecc.) e stimolo della resistenza naturale della pianta.
Dosaggi:
- Radicale: 20 ml per 100 m²
- Tappeto erboso: 20 ml in 100 L per 100 m²
- Alberature: 10-20 ml in 10 L d’acqua/pianta – adattare il dosaggio al volume d’acqua necessario a raggiungere le radici assorbenti
Esempio d’uso: su leccio o platano soggetti a problemi radicali o antracnosi. Applicazione al piede o lungo la proiezione della chioma.
🌱 Bacillium
Micorrize + Bacillus spp. selezionati
Funzione principale: stimolazione della crescita e difesa antibatterica/fungina. Molto utile anche in orticultura e tappeti erbosi.
Dosaggi:
- Radicale: 10-20 ml per 100 m²
- Fogliare: 15-20 ml in 10 L d’acqua
- Tappeto erboso: 20 ml in 10 L per 100 m²
Esempio d’uso: su ortaggi o piante aromatiche come rosmarino o salvia, per prevenire marciumi radicali o muffe durante l’estate. Oppure in caso di attacchi di: Fusarium spp., Sclerotinia spp., Pythium, Rhizoctonia solani (macchia bruna), Botrytis cinerea (muffa grigia), cancro batterico, maculatura comune, necrosi batterica.
🌾 Bioseed
Micorrize (5%) + batteri della rizosfera
Funzione principale: miglioramento radicale e della fertilità microbiologica del suolo, ideale per nuove piantumazioni o giardini stanchi. I microrganismi, sviluppandosi, producono una serie di metaboliti utili alla pianta, innalzandone le proprie difese naturali, oltre a inibire lo sviluppo di specie fungine patogene.
Dosaggio:
- Radicale: 20-40 ml per 100 m²
Esempio d’uso: nel primo anno di vita di giovani alberi da frutto o ornamentali, per favorire attecchimento e crescita.
🐛 Turikum
Micorrize + batteri della rizosfera + Bacillus thuringiensis (insetticida naturale)
Funzione principale: controllo biologico di larve di lepidotteri (nottue, tignole, processionaria).
Dosaggi:
- Radicale: 10 ml per 100 m²
- Alberature: 10-20 ml in 10 L d’acqua/pianta
Nota importante: agisce per ingestione → è fondamentale bagnare bene la vegetazione.
Esempio d’uso: su cipressi o pini soggetti a processionaria, in trattamenti precoci, oppure su rosai attaccati da nottue.
Consigli finali
- Sempre abbinare a Nutribio N per attivare i microrganismi. Usare in dose di 1-2 litri/100 litri d’acqua (1 litro se si tratta ogni mese, se no 2 per unico trattamento)
- Evitare le ore più calde o i giorni di pioggia
- Preferire terreni ben drenati ma leggermente umidi
- Evitare trattamenti dopo l’uso di fungicidi o insetticidi chimici, sarebbero inutili
- Agitare bene i flaconi prima dell’uso per riattivare le spore
Tabella dei dosaggi
Vuoi tenere sempre sotto mano i dosaggi?
Scarica e stampa questa infografica completa con tutti i dosaggi e gli utilizzi dei prodotti Unmaco a base di microrganismi biostimolanti. Uno strumento pratico per ogni appassionato di giardinaggio!

Add Comment